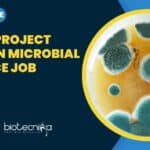
IMTECH Microbiology Project Research
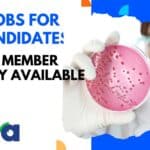
Cipla Jobs For BSc

Home Search
microbiology - search results
If you're not happy with the results, please do another search
CSIR Inviting Online Applications For Direct SRF & RA – Latest Notification
CSIR Direct SRF RA Online Applications
Council of Scientific and Industrial Research
Human Resource Development Group
Extramural Research Division-I
ADVERTISEMENT - 2023/1)
INVITING APPLICATIONS FOR direct SRF and RA
Only...
Biotecnika Times Newsletter 14.04.2023 Internship, Freshers Jobs, Govt ILS Recruitment
Biotecnika Times Newsletter 14.04.2023 Internship, Freshers Jobs, Govt ILS Recruitment
Zero Meat Internship - Food Science & Food Tech Candidates Apply For Product Development Intern
Food...
IMTECH Project Based On Microbial Resource Job Opening, Apply Online
IMTECH Microbiology Project Research Job Opening, Apply Online
IMTECH Microbiology Project Research Job Opening, Apply Online. MSc Natural and Agricultural Sciences Project job. Project Associate...
Biotecnika Times Newsletter 13.04.2023 Internships, Cipla Hiring, IQVIA Jobs, Cognizant + Much More
Research & Development Intern at Jana Care For BSc Biotech & Life Sciences
Research & Development Intern at Jana Care For BSc Biotech & Life...
ICMR-NIRRCH Non-Med Scientist Job For MSc & PhD Candidates, Apply Online
ICMR-NIRRCH Non-Med Scientist Job For MSc & PhD Candidates, Apply Online
ICMR-NIRRCH Non-Med Scientist Job For MSc & PhD Candidates, Apply Online. NIRRH recruitment for...
NARI Tech Officer Job For BSc, MSc & PhD Candidates From Life Sciences
NARI Tech Officer Job For BSc, MSc & PhD Candidates From Life Sciences
NARI Tech Officer Job For BSc, MSc & PhD Candidates From Life...
Cipla Jobs For BSc Candidates – Jr. Team Member Vacancy Available
Cipla Jobs For BSc Candidates - Jr. Team Member Vacancy Available
Cipla Jobs For BSc Candidates - Jr. Team Member Vacancy Available. BSc Microbiology Jobs....
Biotecnika Times Newsletter 12.04.2023 Govt Jobs Bonanza, Top Research Areas, CSIR NET 50 Day...
Biotecnika Times Newsletter 12.04.2023 Govt Jobs Bonanza, Top Research Areas, CSIR NET 50 Day Plan
Govt NCT Delhi ILBS Biotech, Life Sciences & Immunology JRF...
Govt NCT Delhi ILBS Biotech, Life Sciences & Immunology JRF Job Opening, Applications Invited
ILBS Immunology JRF Job - Biotech & Life Sciences Apply
ILBS Immunology JRF Job - Biotech & Life Sciences Apply. Junior Research Fellow job opening...
Clarivate Drug Safety Content Specialist Job For MSc Biotech, Biochem, Life Sciences
Clarivate Drug Safety Content Specialist Job For MSc Biotech, Biochem, Life Sciences
Clarivate Drug Safety Content Specialist Job For MSc Biotech, Biochem, Life Sciences,...
Biotecnika Times Newsletter 11.04.2023 Freshers Jobs, Research Associate Fellowship Programme, CSIR NET Notes, CSIR...
Biotecnika Times Newsletter 11.04.2023 Freshers Jobs, Research Associate Fellowship Programme, CSIR NET Notes, CSIR Exam Application Date Extended
Freshers Graduate/Post Graduate Life Sciences QA Job...
Biotecnika Times Newsletter 10.04.2023 Himedia 0-1 Year Exp Job, THSTI Bioinformatics Jobs, Gene Mapping...
Biotecnika Times Newsletter 10.04.2023 Himedia 0-1 Year Exp Job, THSTI Bioinformatics Jobs, Gene Mapping Notes + Much More
HIMEDIA Bioinformatics Analyst Job For Candidates With...
Chittaranjan National Cancer Institute (CNCI) MSc Biology & Life Sciences JRF Jobs, Applications Invited
CNCI Biology JRF Jobs Opening - Life Sciences Can Also Apply
CNCI Biology JRF Jobs Opening - Life Sciences Can Also Apply. Chittaranjan National Cancer...
Biotecnika Times Newsletter 07.04.2023 Central Silk Board Jobs 2023, PhD Admissions, Workshops
Biotecnika Times Newsletter 07.04.2023 Central Silk Board Jobs 2023, PhD Admissions, Workshops
CMERTI Silk Board BSc & MSc Life Sciences Jobs Available, Attend Walk-In
CMERTI Silk...
iD Fresh Foods Research Scientist Job Available, Apply Online
iD Fresh Foods Research Scientist Job Available, Apply Online
iD Fresh Foods Research Scientist Job Available, Apply Online. MTech Food Microbiology/ Food Biochemistry/ Food Chemistry...